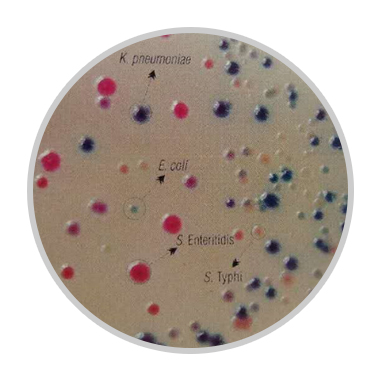
9款沙门氏菌显色培养基概览
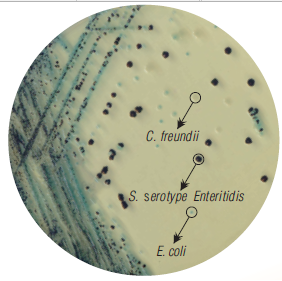
9款沙门氏菌显色培养基概览
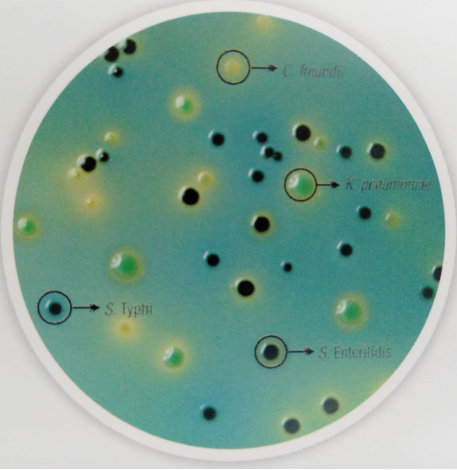
9款沙门氏菌显色培养基概览

9 年
手机商铺
公司新闻/正文
395 人阅读发布时间:2018-09-12 13:44
沙门氏菌包括2300种血清型,其中肠炎沙门氏菌和鼠伤寒沙门氏菌大约占人类所有感染的一半。大多数感染可追溯到奶制品、禽类和肉制品,但沙门氏菌可在任何食物上生长。鸡肉、蛋及蛋制品尤其具有很高的风险。
沙门氏菌大多数菌种为兼性厌氧菌,不发酵乳糖,但可发酵葡萄糖,产酸产气,过氧化氢酶阳性,氧化酶阴性,革兰氏阴性,有动力。
用于区分和鉴别沙门氏菌的培养基是基于糖发酵及pH变化,蛋白裂解活性及的产生。传统依靠来鉴别的方法特异性不强,因为一些非沙门氏菌也产生,如柠檬酸杆菌和奇异杆菌,因此还需要下游的鉴定试验。
近十年来开发的针对沙门氏菌特异性酶的显色培养基更加可靠,它的检出率和准确度都高于传统的培养基。
HiMedia提供有9款沙门氏菌显色培养基,如果挑选符合国标优选的,当属
MV1296,它用于分离和鉴别沙门氏菌,与大肠菌群相区分,同时不含动物源成分,从而避免疯牛病风险。沙门氏菌呈淡紫色菌落,并有紫色光晕。大肠杆菌和其他β-葡萄糖醛酸酶阳性菌都显示为蓝色,其他微生物菌落为无色。

图1. MV1296
M1842这款也可用于分离沙门氏菌,它增加了氮源营养,提供了胆盐的用量,也需要添加剂,内含头孢类抗生素,增加了选择性。这款显色培养基也有化学限定型的。
MV1466是一款增加鉴别力的显色培养基。奇异变形杆菌在上面生长为淡棕色,大多数沙门氏菌为粉红色,伤寒沙门氏菌为淡粉色。这款显色培养基也有化学限定型。
MV1078是在时间上更早的显色培养基,价格也非常合适。它们是一款鉴定和鉴别培养基,特别用于区分沙门氏菌和变形杆菌,但无法挑出伤寒沙门氏菌,因为它和变形杆菌都是无色。这款培养基也有化学限定的。MV1082是MV1078的改良型,每升培养基增加了5克氯化钠和1克酵母粉。
图2. MV1078
以上培养基都利用了沙门氏菌代谢丙二醇的特点。下面M1633和M1634两款培养基与之不同,他们与XLD培养基一样,都利用了乳糖发酵的原理进行区分。伤寒沙门氏菌在M1633上为无色,但随时间延长会显示粉红色,而在M1634上会一直是无色。
MV1393是用于水和临床样本中鉴定和区分沙门氏菌和非沙门氏菌如柠檬酸杆菌。培养基中的甘露醇、纤维二糖和海藻糖刺激沙门氏菌生长,但这些糖浓度很低,不会干扰H2S的产生。培养基中的乳糖能抑制柠檬酸杆菌产生H2S。因此,沙门氏菌为黑色中心,大肠菌群为蓝绿色。
图3. MV1393
M1816是MV1393的改良型,它增加了纤维二糖和蔗糖的含量。在它上面生长的大肠菌群为黄色或黄绿色,变形杆菌为灰色,鼠伤寒为黑色中心,但肠炎沙门氏菌为黑色中心的同时带有黄色光晕。该培养基也有化学限定型的。
图4.M1816